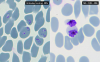
These images show the malaria parasites before and after treatment. Without MK-7602, parasites (purple) invade red blood cells (blue) after two days. With MK-7602, they are trapped inside cells, halting the malaria cycle and blocking transmission.

New antimalarial drug candidate shows potential for fighting resistance and reducing malaria transmission
WEHI

Researchers have developed a new antimalarial drug candidate designed to address the growing challenge of drug resistance and potentially reduce malaria transmission.
The first-in-class clinical candidate, MK-7602, has been developed through a longstanding collaboration between WEHI and global biopharmaceutical company MSD (tradename of Merck & Co., Inc., Rahway, N.J., USA).
Pre-clinical research now published in eBiomedicine, a Lancet journal, shows the novel drug candidate targets the malaria parasite at multiple stages of its life cycle, with potential applications for both treating infections and reducing disease spread.
Since the completion of this preclinical research, results from early stage clinical trials continue to provide evidence for the potential of MK-7602 for the treatment of malaria.
At a glance
- First-in-class antimalarial drug candidate MK-7602 shows potent activity against both Plasmodium falciparum and Plasmodium vivax, the two most common malaria parasites affecting humans.
- Evidence suggests the compound's dual-action mechanism, targeting two essential parasite enzymes, may help combat the development of drug resistance.
- The drug candidate has been developed through a longstanding collaboration between WEHI and MSD, with pre-clinical studies indicating a promising safety profile and pharmacokinetic properties.
Working to advance the fight against malaria
The emergence of drug-resistant parasites has complicated efforts to control and eliminate malaria, which remains a leading cause of preventable illness and death globally, killing an estimated 600,000 people a year.
Children under 5 are the most vulnerable – it is estimated that a child dies of malaria every minute.
The new drug candidate MK-7602 targets the most prevalent malaria parasites in humans, Plasmodium falciparum and Plasmodium vivax, and blocks two essential parasite enzymes, providing a unique dual-action strategy with the potential to reduce the risk of resistance.
Professor Alan Cowman AC, lead investigator from WEHI, said new and better treatments for malaria were urgently needed, to drive forward global efforts towards eradication.
“The evaluation of MK-7602 represents an important step in our fight against malaria,” he said.
“Its ability to target multiple stages of the parasite life cycle, combined with its high barrier to resistance, supports our ongoing efforts to find new ways to combat this devastating disease for patients who need the hope of new treatments.”
“We are encouraged by these results and look forward to further investigating this candidate as a potential new tool in malaria control and elimination efforts.”
Collaborative drug development effort
The close research collaboration between WEHI and MSD, spanning almost a decade, used the advanced screening technologies at WEHI's National Drug Discovery Centre, which were instrumental in identifying and optimising the compound.
The new study combined mouse models and laboratory tests using human blood cells to evaluate the activity of MK-7602 against malaria parasites at multiple life stages, including the blood, liver and transmission stages.
Its mechanism targets two essential parasite enzymes, Plasmepsin IX and X, with the goal of creating a high barrier to the development of resistance.
MK-7602 has since completed Phase 1 safety and tolerability studies. Results of a Phase 1b clinical trial evaluating the activity of MK-7602 against P. falciparum blood stage infection in healthy adult participants (NCT06294912) were recently presented at the American Society of Tropical Medicine & Hygiene (ASTMH) meeting.
Further studies are needed to fully assess the efficacy and safety of MK-7602 in diverse patient populations and real-world settings.
This research was supported by Wellcome, Drakesnberg Trust and the National Health and Medical Research Council of Australia.
The study, “MK-7602: a potent multi-stage dual-targeting antimalarial”, is published in eBiomedicine, a Lancet journal (DOI: 10.1016/j.ebiom.2025.106061).
About us:
About WEHI (Walter and Eliza Hall Institute of Medical Research)
WEHI is where brilliant minds collaborate and innovate to make life-changing scientific discoveries that help people live healthier for longer. Our medical researchers have been serving the community for more than 100 years, making transformative discoveries in cancer, infection and immunity, and lifelong health. WEHI brings together diverse and creative people with different experience and expertise to solve some of the world’s most complex health problems. With partners across science, health, government, industry, and philanthropy, we are committed to long-term discovery, collaboration, and translation. At WEHI, we are brighter together.
Find out more at www.wehi.edu.au
Contact details:
M: +61 475 751 811
E: [email protected]